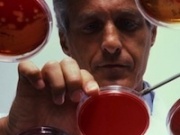

Самые новые лекарства для лечения гепатита С
16 августа | | Посмотрели: 2181
В настоящий момент терапия гепатита С соответствующими медикаментами излечивает немногим более 40 процентов больных. Притом у выздоровевших обнаруживается очень много проблем со здоровьем, вызванных приёмом препаратов. Согласно информации фармацевтических лабораторий Америки совсем скоро в производство будет запущен целый ряд новых лекарств для лечения гепатита.
Предполагается, что такие лекарства для лечения гепатита С будут более действенными (на 30 процентов), а побочных эффектов станет существенно меньше. Этими препаратами станут boceprevir и Vertex. Также данные лекарства окажут воздействие на скорейшее выздоровление больного с хроническим гепатитом С. Поскольку недуг развивается от двух- четырех месяцев до десятков лет, то многие пациенты, которые родились в период с начала 50-х и по 70-е не проходят обследования и даже не думают, что больны гепатитом, что в результате приводит к запущенной неизлечимой форме.
Основной сложностью лечения хронического гепатита С является несвоевременная диагностика и очень дорогие препараты используемые при лечение этого недуга. На данный момент самым лучшим средством лечения гепатита является терапия интерфероном вместе с рибавирином. Благодаря этому варианту лечения можно добиться некоторых успехов.
Но данные лекарства стоят очень дорого, что накладывает определенный отпечаток на лечение. Однако сегодня появились и российские аналоги, которые дешевле в несколько раз и лечение таковыми можно довольно продолжительное время. Но отечественные лекарства для лечения гепатита С обладают несколько меньшим эффектом. Еще одним из недостатков этих лекарств является наличие огромного числа подделок. Потому при их покупке непременно требуйте сертификаты качества.
Предполагается, что такие лекарства для лечения гепатита С будут более действенными (на 30 процентов), а побочных эффектов станет существенно меньше. Этими препаратами станут boceprevir и Vertex. Также данные лекарства окажут воздействие на скорейшее выздоровление больного с хроническим гепатитом С. Поскольку недуг развивается от двух- четырех месяцев до десятков лет, то многие пациенты, которые родились в период с начала 50-х и по 70-е не проходят обследования и даже не думают, что больны гепатитом, что в результате приводит к запущенной неизлечимой форме.
Основной сложностью лечения хронического гепатита С является несвоевременная диагностика и очень дорогие препараты используемые при лечение этого недуга. На данный момент самым лучшим средством лечения гепатита является терапия интерфероном вместе с рибавирином. Благодаря этому варианту лечения можно добиться некоторых успехов.
Но данные лекарства стоят очень дорого, что накладывает определенный отпечаток на лечение. Однако сегодня появились и российские аналоги, которые дешевле в несколько раз и лечение таковыми можно довольно продолжительное время. Но отечественные лекарства для лечения гепатита С обладают несколько меньшим эффектом. Еще одним из недостатков этих лекарств является наличие огромного числа подделок. Потому при их покупке непременно требуйте сертификаты качества.
Читайте так же: